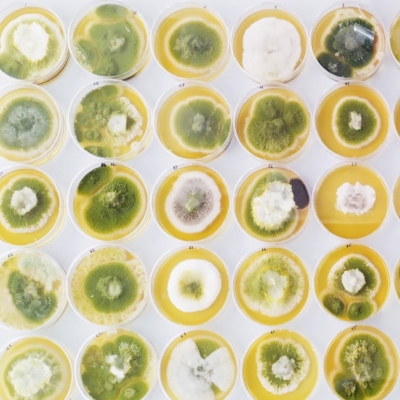

Welcome to this online, self-pace course which can be started at any time until February 2027.
Start your journey now to lead a change towards reduction of aflatoxin contamination throughout your peanut supply chain.
At a glance
-
- Dates
-
- Please enquire for course dates
- DurationEstimated 30 hours of work at your own pace.
- LocationOnline
- Cost£680
Why enrol in this course?
- Expert insights and personalised feedback - gain exclusive knowledge from leading experts in food safety and mycotoxin management. Benefit from a 1-to-1 feedback session with a researcher to address your specific challenges and implement practical strategies that deliver results.
- Unlock food safety success - Develop a plan towards efficient Hazard Analysis and Critical Control Point approach and start your journey towards compliance with Codex Alimentarius, USA, European and UK regulations. Equip yourself with tools to enhance food safety, boost market access, and achieve international standards and safety benchmarks.
Course structure

Register
The course is developed in five sections, carefully articulated around the following sections:
- Introduction to food mycology
- Introduction to mycotoxin
- Mycotoxins regulation and detection
- Aflatoxin in the peanut food chain
- Aflatoxin impact in a changing socio-economic context
Each section includes the assimilation of several theoretical, practical and case study activities carefully designed in our CANVAS learning platform. Throughout the sections, you will develop your own workbook including an action plan on how to tackle aflatoxin challenges within your own supply chain environment. At the end of the course, you will have the outstanding opportunity to have a one-to-one online meeting with one of our researchers to provide you tailored feedback on your workplan.
What you will learn
The course examines the current state-of-the-art knowledge on aflatoxin management in peanuts into an interactive learning interface for everyone independent of their education background.
This course will help you to understand and apply key fundamental concepts linked with fungal growth and mycotoxin contamination before providing success-stories in reducing aflatoxin contamination at each stage of the supply chain. Our goal is for you to assimilate and critically discuss the different mitigation strategies available and identify which to prioritise and how to implement them within your on research/industrial context.
Who should attend
This training is suitable to anyone interested in aflatoxin challenges in the peanut food chain. Are you a Farmer? Merchant? Policy maker? Government employee? Manager? Agronomist? Or just want to learn more about the challenges related to the safety of your morning peanut paste, then this course is for you!
No scientific degree nor background is requested although a good use of English and previous experience with aflatoxin challenges is appreciated.

Empower yourself with the knowledge to safeguard peanut quality and consumer health. Learn the best practices for preventing and controlling Aflatoxin contamination, from farm and beyond the farm gates. This course helped me to take the lead in ensuring food safety and industry compliance.
Excel Jeff Agboola, Lecturer, Ondo State University, Nigeria
Location and travel
Fully online with an end one-to-one online meeting with a scientist.Read our Professional development (CPD) booking conditions.